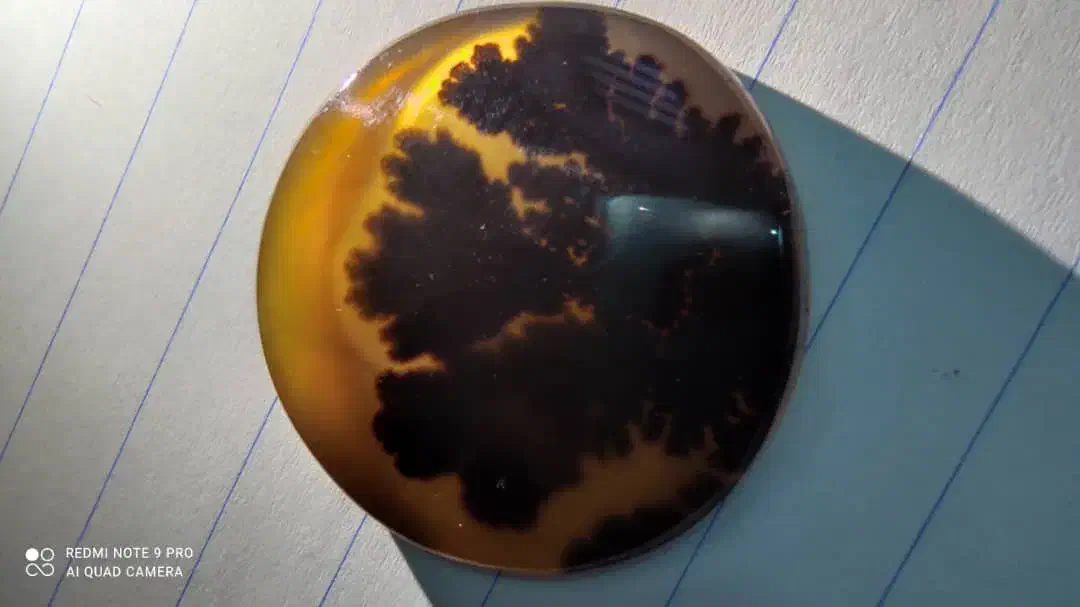

سنگ مصور قائنات تک درخت با منظره غروب
توضیحات
سنگ بسیار زیبا و بسیار نادر و کمیاب تک درخت قائنات و مصور که تصویر صورت یک مرد از بقل رو به نمایش گذاشته که صفر تا صد نقاشی و شاهکار طبیعت میباشد. کاملا معدنی و طبیعی میباشد با زمینه غروب مانند که زیبایی سنگ رو چندین برابر زیباتر و خاص تر کرده است ، تراش مناسب آویز میباشد به دلیل بزرگ بودن سنگ و تراش نگین سکه ایی میباشد و حالت سه بُعدی تراش خورده است [[[[ به دلیل کلکسیونی بودن سنگ و کمیاب بودن چنین نمونه ایی قیمت مقطوع میباشد]]]
یادداشت تنها برای شما قابل دیدن است و پس از حذف آگهی، پاک خواهد شد.